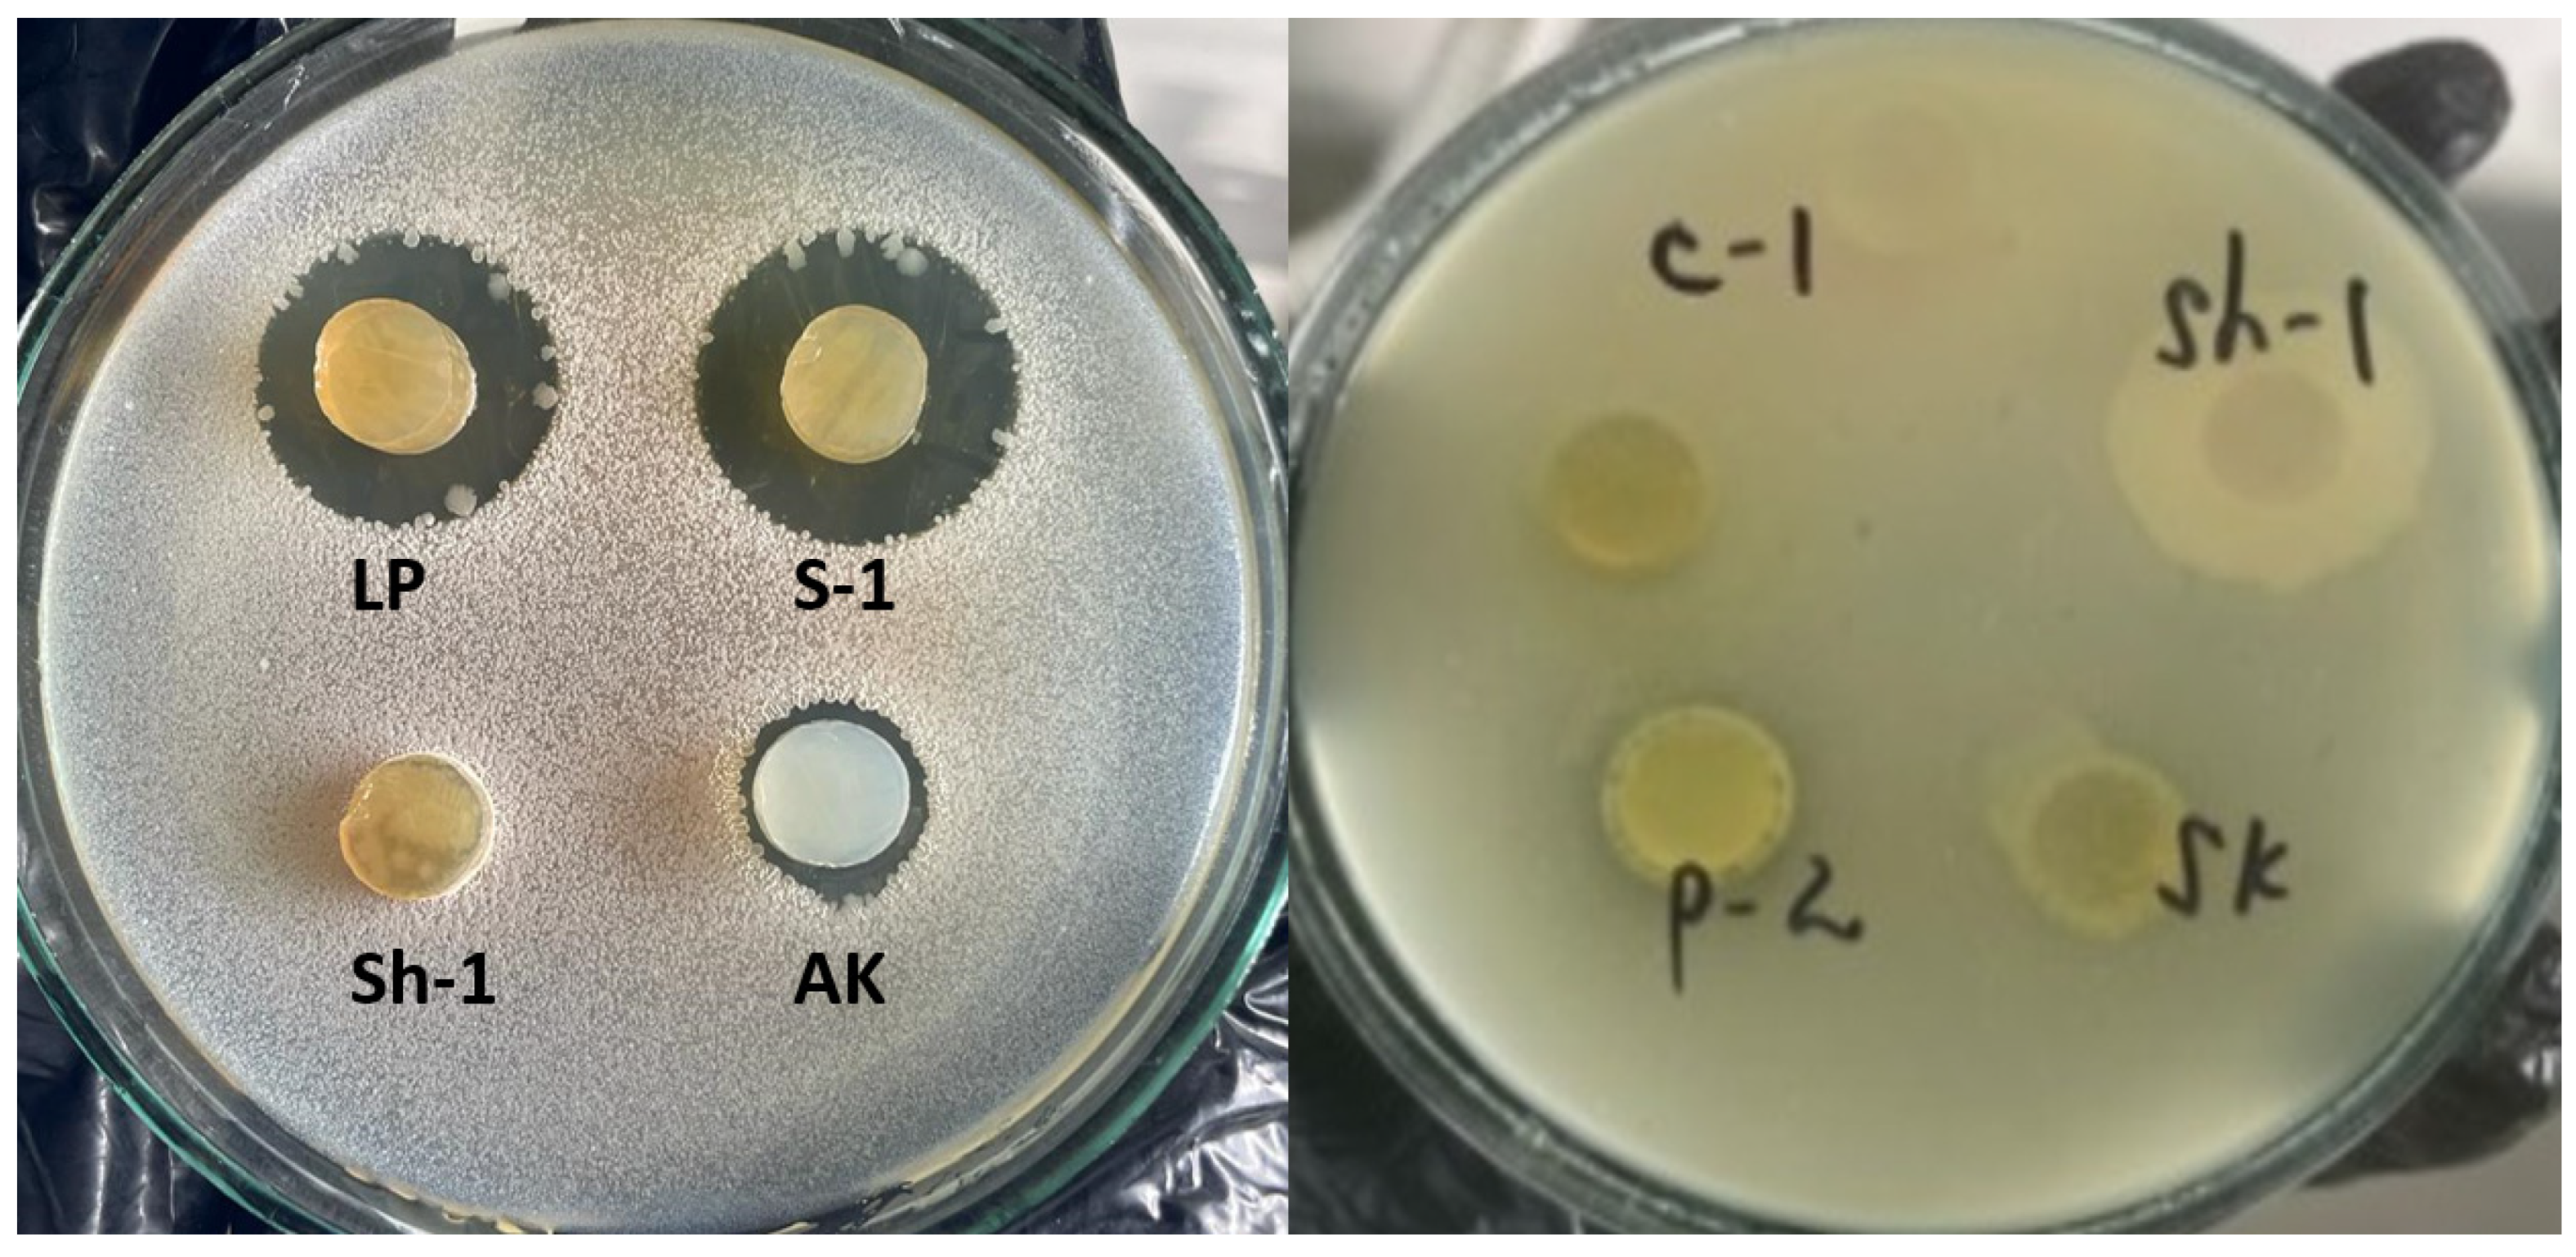
Microbiolres 15 00087 g001

1. Introduction
In the dynamic landscape of microbiology, a pressing area of focus lies in the quest for microorganisms with antimicrobial activity. This pursuit is driven by a significant global challenge: the rise of antibiotic-resistant strains, pathogens of infectious diseases displaying resistance to a broad spectrum of antibiotics. Over time, microorganisms evolve, either losing their biological properties or adopting aggressive traits toward humans. The acquisition of new probiotic microorganisms presents a promising avenue to address the challenge of effective treatment. It is well-established that probiotics exert an anti-infective, immunomodulatory effect on the body. They bolster barrier functions, fortifying defenses against bacteria, viruses, and harmful substances, while also enhancing intestinal motility and excretory functions. Probiotics offer effective treatment avenues for allergies, impaired intestinal motility, inflammatory bowel diseases, and lactase deficiency [
1,
2].
The efficacy of microbial preparations hinges on their antagonism towards opportunistic and pathogenic microflora, their high adhesiveness, restoration of normal microflora in the biotope, and vitamin production. The increasing demand for probiotics is intertwined with the evolution of pathogens causing infectious diseases, coinciding with a societal trend toward embracing healthy lifestyles. This trend includes the widespread use of dietary supplements containing probiotic microorganisms.
The World Health Organization (WHO) defines probiotics as “live microorganisms that, when administered in adequate quantities, confer a health benefit on the host” [
3]. Notably, all probiotics must be safe for their intended use; dead microbes, microbial products, or components do not fall under the classification of probiotics. While commensals in the gut or food cultures often serve as sources of probiotic strains, it is essential to note that these strains must undergo isolation, characterization, and rigorous validation of their health effects before earning the designation of “probiotics” [
1,
4].
Probiotics are commercially available in foods, dietary supplements, and pharmaceuticals. For a probiotic to be effective, it must be live, safe, and administered in an effective dose to the target tissue. The characterization of promising probiotic strains is a multifaceted process. They must exhibit functionality, safety for human consumption, and resilience against various factors encountered during the processing, storage, and consumption of food products. Probiotic cultures hold immense potential, including lactobacilli, bifidobacteria, lactic streptococci, enterococci, bacilli, and yeast [
1]. These microorganisms have been classified by origin into distinct groups [
5,
6]:
Group 1: Fermented Milk Strains: (Lactobacillus acidophilus, Lactobacillus plantarum, Lactobacillus bulgaricum, Lactobacillus fermentum, Lactococcus casei, Streptococcus thermophiles, Enterococcus sp., Bifidobacterium lactis).
Group 2: Donor Strains: (Bifidobacterium bifidum, Bifidobacterium longum, Bifidobacterium infantis, Bifidobacterium adolescentis, Lactobacillus rhamnosus, Lactobacillus gassed, Enterococcus faecium, Enterococcus salivarius).
Group 3: Antagonists: (Bacillus subtilis, Saccharomyces boulardii).
Each year, scientists unveil new strains, each unique in its potential. Antagonism against opportunistic and pathogenic microorganisms is of paramount significance. These antagonists exhibit inhibitory effects on bacteria, yeast, actinomycetes, and filamentous fungi, leading to the development of numerous probiotic products in medicine, veterinary medicine, lactic acid products, cosmetics, and detergents.
The antiseptic properties of probiotics stem from their enzymatic activity, bacteriocin production, ethanol, organic acids, and other biologically active substances [
7]. Lactic acid bacteria (LAB) have received significant attention as probiotic sources for decades [
8]. These bacteria play pivotal roles in metabolism, vitamin production, and enzyme synthesis, and support the biocenosis of human biotopes. They exhibit diverse effects, including immunomodulatory, carcinogenic, and antimutagenic properties [
9].
Traditional Kazakh dairy products, deeply rooted in the country’s cultural heritage, have long been cherished for their rich flavors and nutritional benefits. Among these, kurt, butter, kaymak, irimshik, ayran, kumis (qymyz), and shubat stand out as quintessential examples, each reflecting the traditional knowledge and culinary practices of the region. Beyond their gustatory appeal, these dairy products hold significant promise as sources of probiotic microorganisms, offering potential health benefits to consumers [
10,
11]. Kurt is a national dessert that can be either salty or sweet and can have a liquid, solid, or powdered consistency. It is made from any type of milk. The shapes vary: round, rectangular, or cylindrical. Kurt is produced by fermenting milk with lactic acid bacteria cultures, similar to the process for liquid kurt. However, after fermentation, the product is typically pressed and dried to remove excess moisture, resulting in a firm texture. Kaymak is traditionally made by skimming the cream from milk and then heating it gently until a thick layer of cream forms on the surface. This cream is then collected and cooled, resulting in the creamy kaymak product. Ayran is a traditional yogurt-based beverage popular in Kazakh cuisine [
11].
Our study uniquely focuses on isolating probiotic strains from milk and dairy products across Kazakhstan, a region underrepresented in probiotic research. We employed advanced 16S rRNA and ITS gene sequencing along with the delayed antagonism method to ensure precise identification and comprehensive antimicrobial activity assessment. Unlike previous studies, we evaluated resistance to multiple environmental stress factors, highlighting the robust industrial potential of strains like Lactiplantibacillus pentosus LP and Lacticaseibacillus casei AK. The results of this study, particularly the isolated microorganism cultures, are both novel and original, resonating with research conducted worldwide. The research tackled a range of objectives, including the isolation of probiotically promising bacteria, stress factor resistance assessment, pathogen antagonism studies, and bacterial and yeast identification via nucleotide sequence analysis.
2. Materials and Methods
2.1. Extraction of Isolates and Cultivation Conditions
Industrial products consisted of kaymak, ayran, and yogurt, while homemade products consisted of liquid and hard kurt, butter, ayran, and starter cultures. In addition, fresh milk from the cow and the goat was collected from the local farm. A total of 24 dairy product samples were collected (
Table 1). Isolation of a pure culture involves three stages: obtaining an enrichment culture, isolation of pure culture, and determination of its purity [
12]. To isolate milk microorganisms, MRS medium was used—Mann, Rogosa, Sharp medium (manufactured by HiMedia Laboratories Pvt. Ltd., Mumbai, Maharashtra, India), and homemade cabbage agar. Cabbage agar was prepared as follows: 200 g of finely chopped fresh cabbage was added to 1 L of tap water. The mixture was brought to a boil and boiled for 10–14 min. It was then filtered through cotton gauze. The obtained filtrate was diluted with water two times, then 20 g of glucose, 10 g of peptone, and 10 g of calcium carbonate were added to it. A 15–20 g amount of agar was melted in the mixture by heating. The pH of the medium was adjusted to 7.0–7.4 and poured into flasks. Sterilization was carried out for 20 min at a temperature of (121 ± 1) °C.
Isolation of cultures from solid products such as cheese, butter, and kurt was carried out by homogenizing 10 g of the product in 90 mL of physiological solution and grinding in a porcelain mortar. The liquid material was immediately added to the liquid medium.
The starting material was transferred into 2 tubes with 5 mL of De Man, Rogosa, and Sharp broth and incubated under microaerophilic conditions in BBL™. CampyPak™Plus system (BD, Franklin Lakes, NJ, USA) for 72 h at 37 °C and under normal conditions in a thermostat at 37 °C for 18–24 h. Then the enrichment culture was sown in Petri dishes on the surface of MRS agar and cabbage agar with incubation at 37 °C for 24–48 h with further study of the cultural properties and morphological properties by microscopy of Gram-stained smears.
Purity is determined by the uniformity of growth on the medium and the uniformity of cells in the smear. The affiliation of the grown microorganisms with lactic bacteria (lactobacteria, lactococci, lactic streptococci) was identified based on their properties and microscopy: cell morphology (rods, cocci), tinctorial properties, location, absence of spores; lack of catalase; mobility; growth on dry nutrient agar (lactobacilli are characterized by a lack of growth) [
13].
Sterility control of each batch of culture media was performed by incubating the media in a thermostat at 37 °C for 18–24 h after pouring. No microbial growth was observed, and all media were sterile. The sterility of the boxed rooms was checked by air plating onto Petri dishes with various media (sedimentation method).
2.2. Determination of the Maximum Viability Index
Determination of the maximum viability index (MVI) of microorganisms was conducted using the Miles and Misra method [
14]. The culture was washed into a separate tube with MRS broth; to prepare dilutions, the physiological solution was poured into 9 mL; 1 mL of the initial suspension was added to the first test tube—this is the 1st dilution (10
−1); titration was carried out to 10
−10. Then, the outer back of the Petri dish was divided into eight equal sectors. A precisely measured volume of bacterial suspension (20 μL) was applied as a drop onto the surface of the medium in sectors using a sterile pipette. Inoculations on solid medium were carried out, as a rule, from the last eight dilutions. The cultures are incubated and then the number of colonies grown is determined.
The number of cells in 1 mL of the test substrate is calculated using Equation (1):
where
M is the number of cells in 1 mL;
a—the average number of colonies;
10n—dilution ratio;
V—volume of suspension taken for inoculation, in ml;
50—conversion factor from µL to ml.
The studies were carried out in triplicate and average values were calculated.
2.3. Growth of Microorganisms under Stress Conditions
Growth under different temperatures
Cultures were inoculated in an amount of 0.5 mL per 8–10 mL of MRS broth into 4 test tubes at temperatures of 15, 27, 50, and 65 °C. The samples were incubated for 2 days. The growth or lack of growth of the culture is noted visually (after shaking the tube) by the presence or absence of turbidity [
15].
Growth under different pH conditions
Cultures were inoculated in an amount of 0.5 mL per 8–10 mL of MRS broth into 3 test tubes for testing at different pH levels: 3–4; 6.8–7.0; 8.0–9.6. The samples were incubated at 39 °C for 2 days. The growth or lack of growth of the culture is noted visually (after shaking the tube) by the presence or absence of turbidity [
15].
Growth at different salt concentrations
Cultures were inoculated in an amount of 0.5 mL per 8–10 mL of MRS broth with different salt contents (NaCl, 2%, 4%, 6%). The samples were incubated at 39 °C for 2 days. The growth or lack of growth of the culture is noted visually (after shaking the tube) by the presence or absence of turbidity [
15].
Growth at different ethanol concentrations
In tubes containing 5 mL of MRS broth, the following concentrations of ethanol were added: 2%, 4%, 6%, 8%. Then, 0.5 mL of culture was inoculated into each tube. After 24 h, the presence or absence of growth was recorded [
15].
Growth at different glucose concentrations
In tubes containing 5 mL of MRS broth, the following concentrations of glucose were added: 30%, 40%, and 50%. Then, 0.5 mL of culture was inoculated into each tube. Cultivation was carried out at 39 °C. After 24 h, the presence or absence of growth was recorded [
15].
Growth with the addition of peroxides—hydrogen peroxide
In tubes containing 5 mL of MRS broth, the following concentrations of hydrogen peroxide were added: 2 mmol/L, 6 mmol/L, 8 mmol/L. Then, 0.5 mL of culture was inoculated into each tube. Cultivation was carried out at 39 °C. After 24 h, the presence or absence of growth was recorded [
15]. All studies to assess stress resistance were carried out in triplicate.
2.4. Study of the Antimicrobial Activity of Isolated Cultures against Opportunistic Microorganisms
Isolates selected were inoculated into fresh MRS broth and incubated overnight at 37 °C [
16,
17,
18,
19]. The cell suspension of overnight antagonist cultures was prepared at a concentration of 1 billion/1 mL (according to the bacterial turbidity standard), and then 100 µL of the inoculum was spread onto the surface of nutrient agar plates using a spreader. After allowing the inoculum to dry, wells were cut into the agar using a sterile cork borer (10 mm diameter). Each well was filled with 100 µL of suspension from each of the tested cultures. After incubation at 37 °C for 24–48 h, inhibition zones around the wells were observed. The diameter of the inhibition zone was measured in millimeters, and a clear zone of 1 mm or more was considered positive inhibition. Results were categorized as follows: “0” degree—up to 1.0 mm, low—1.1–4.9 mm, moderate—5.0–8.9 mm, high—9.0 mm and above. The experiments were conducted in triplicate
Indicator test strains, including Gram-negative bacteria
Escherichia coli 209-P,
Pseudomonas sp., Gram-positive bacteria
Staphylococcus aureus 209-P,
B. subtilis ATCC 6633, as well as the yeast
Candida albicans ATCC 885-653, are stored in the laboratory collection. Indicator organisms, except for the yeast culture, were grown conventionally to the stationary phase in a nutrient broth medium (“HiMedia Laboratories Pvt. Ltd.”, India) at 37 °C under aerobic conditions. C. albicans ATCC 885-653 was subcultured and grown in Sabouraud broth (“HiMedia Laboratories Pvt. Ltd.”, India) at 37 °C under aerobic conditions. Prior to the experiment, overnight cultures were adjusted to a homogeneous bacterial concentration of 1.0 × 10
7 CFU/mL using spectrophotometry (OD 600) and stored under cooling conditions at −4 °C [
12].
2.5. Identification of Bacterial and Yeast Isolates by Analysis of the Nucleotide Sequence of the 16S Gene pRNA and ITS Gene
For DNA extraction, bacterial DNA from each unidentified test isolate was extracted using the DNA/RNA-C-FACTOR kit as recommended by the manufacturer. DNA extraction from fungal mycelium was carried out using CTAB. DNA concentration was determined spectrophotometrically using a NanoDrop 1000 device (Thermo Scientific, Waltham, MA, USA).
Amplification of the 16S rRNA gene fragment
The PCR reaction for bacteria was performed with universal primers [
20] 8f (5′-AgAgTTTgATCCTggCTCAg-3′) and 806R (5′-ggACTACCAgggTATCTAAT-3′) [
21] in a total volume of 30 µL. The PCR mixture contained 25 ng of DNA, 1 U of Maxima Hot Start Taq DNA Polymerase (Fermentas, Waltham, MA, USA) 0.2 mM of each dNTP, 1 PCR buffer (Fermentas, USA), 2.5 mM MgCl2, 10 pmol of each primer. The PCR amplification program included long-term denaturation at 95 °C for 3 min; 32 cycles: 95 °C—30 s, 55 °C—40 s, 72 °C—60 s; final elongation for 10 min at 72 °C; the PCR program was performed using a GeneAmp PCR System 9700 amplifier (Applied Biosystems, Waltham, MA, USA).
Amplification of the ITS gene fragment
The PCR reaction for the yeast ITS gene fragment was performed with universal primers ITS 5—ggaagtaaaagtcgtaacaagg, ITS 4—tcctccgcttattgatatgc in a total volume of 30 μL. The PCR mixture contained 5 μL of DNA, 1 unit. Taq DNA Polymerase (ThermoFisher, Waltham, MA, USA), 0.2 mM each dNTP, 10 × KCl buffer (ThermoFisher, USA), 2.5 mM MgCl2, 10 pmol of each primer. The PCR amplification program included the following values: 94 °C for 5 min; 30 cycles: 95 °C—30 s, 55 °C—40 s, 72 °C—50 s; final elongation 7 min at 72 °C, PCR program was performed using a Simpli thermal cycler Amp Thermal Cycler (Applied Biosystems, USA).
Electrophoretic analysis of amplification products
Analysis of amplified target DNA fragments was carried out by separating DNA fragments in a 1.5% agarose gel in the presence of an intercalating agent—ethidium bromide, which was used for further DNA visualization. Electrophoresis was performed in a PowerPac horizontal electrophoresis chamber using a BioRad Electrophoretic Bath current source. Additionally, 1× TAE buffer was used as an electrode buffer.
Nucleotide sequence determination
Purification of PCR products from unbound primers and deoxynucleotide triphosphates was carried out by magnetic cleaning using magnetic silica gel.
Magnetic particle cleaning
To set up an experiment based on magnetic particles coated with silica gel, we used a PCR product sample in a volume of 15 μL containing DNA, with a concentration of 1 ng/µL. A 0.1% solution of magnetic particles with a particle size of 1–3 μm and a binding buffer was prepared: for this, 10 μL of a 5% suspension of paramagnetic particles coated with silica gel was mixed with 490 μL of binding buffer (20% PEG and 2.5 M NaCl). Magnetic particles washed with 3% HCl were also used to purify the PCR product. To 15 μL of PCR product, 15 μL of 0.1% solution of magnetic beads (unpurified and washed with 3% HCl) in the corresponding binding buffer were added. The samples were mixed on a shaker for 2 min at 1800 rpm. Then they were incubated at room temperature for 10 min. After the DNA/magnetic particle binding stage, the tube was placed on a magnetic stand and the supernatant was removed. Next, the magnets were washed twice with 100 μL of 70% ethanol to remove any remaining contaminants, and then the purified adsorbed DNA was submerged in the elution solution (1× TE, 10 mM Tris HCl pH-8, deionized water). Elution was carried out for 10 min at 60 °C. Then the tube was placed on a magnetic stand, and the purified PCR product was collected [
22].
The sequencing reaction was performed using the BigDye® Terminator v3.1 Cycle Sequencing Kit (Applied Biosystems) followed by fragment separation on a 3730xl DNA Analyzer (Applied Biosystems).
Nucleotide sequence analysis
Nucleotide sequences were analyzed and combined into a common sequence using SeqMan software (version 6.1, DNA Star). Then the terminal fragments (nucleotide sequences of primers, fragments with a low-quality score) were removed, followed by identification in GenBank using the BLAST algorithm.
If the culture was pure and corresponded to the characteristics, isolated colonies grown on solid nutrient media were subcultured for storage onto slanted agar-agar, into the thickness of MRS broth and by cryopreservation in MRS broth at −20 °C with the addition of glycerol (20% by volume).
3. Results
3.1. Extraction of Isolates and Determination of the MVI
From 24 biomaterials (
Table 2) under investigation, 33 pure isolates were obtained.
Table 2 shows the number of viable cells, from 10
3 to 10
9 CFU/mL. As a result, 15 isolates with optimal numbers were selected for further work: 10
8–10
9 CFU/mL. Our data are confirmed by other works in which LAB was isolated with an assessment of probiotic properties and MVI [
23,
24,
25,
26,
27,
28,
29]. The values of active cultures range from 10
8–10
10 CFU/mL [
30].
The identified colonies exhibited various cultural characteristics in terms of color (white, beige), shape (round or irregular), edge (smooth or serrated), surface (smooth or rough), and colony size, ranging from small to large on the MRS agar plate (
Table 3). Colonies were both shiny and matte. Among them, Gram-positive non-sporulating rods, Gram-positive non-sporulating cocci, and Gram-positive yeast cells predominated. As a result, out of 15 isolates, 8 cultures, according to cultural, morphological, and physiological characteristics, are Gram-positive, non-spore-forming, immobile, catalase-negative rods that do not grow on nutrient agar; 5 cultures were Gram-positive, non-spore-forming, nonmotile, catalase-negative cocci; 2 cultures were Gram-positive, motile, polymorphic yeast cells.
3.2. Assessment of Resistance to Stress Factors
Selected cultures of microorganisms were examined for resistance to stress factors, such as temperature, salts, glucose, ethanol, and peroxide. The results of the stability study are presented in
Table 4.
Regarding temperature, the results are variable. Microorganisms mostly grew at a temperature of 27 °C, with nine cultures growing at 20 °C (60%), three cultures—20% (AK, VD, KS) at 50 °C, and two cultures—13.3% (AK, KS) at 60 °C. The most optimal temperature was 27 °C, 35–37 °C was not assessed since this is the known optimal temperature for isolated microorganisms. Isolates AK and KS can grow at temperatures from 20 to 60 °C.
When assessing the effect of pH on the growth of microorganisms, it was shown that all 15 cultures do not grow at a pH of 3–4; the optimal numbers for them are 6.8–7.0 and 8.0–9.6. Twelve cultures in percentage terms—80%, grow in both intervals of environmental reactions.
Under the growth conditions with different concentrations of NaCl: 2%, 4%, and 6%, it was found that such salt content does not suppress growth, except for culture BD, which does not grow at 4% and 6% sodium chloride. It is known that 10–20% salt leads to the death of microorganisms, so these concentrations were not studied.
Ethanol does not promote microbial growth; a descending progression is noticeable, from 4% to 12% ethanol content in the medium. Eleven isolates (73%) were resistant to 4% ethanol, seven isolates (53.3%) were resistant to 8% ethanol, and only two isolates (13.3%): LP and Str., were resistant to 12% ethanol.
Glucose is the main nutrient source, as evidenced by growth on MRS with different concentrations of glucose (30%, 40%, 50%): all cultures showed growth. However, 60–70% glucose leads to the death of microorganisms, so the concentration was limited to 50%.
Peroxides are known to be detrimental to microorganisms. When peroxides reach concentrations of 11–12 mmol/L in the medium, cultures perish. As a result, we selected concentrations of 2 mmol/L, 6 mmol/L, and 8 mmol/L for our study. Our cultures did not exhibit growth when subjected to varying concentrations of peroxides: 2 mmol/L, 6 mmol/L, and 8 mmol/L. Interestingly, only five isolates (33.3%) showed resistance to a concentration of 2 mmol/L: isolates LP, LB, P-2, C-1, Sh-1. It is noteworthy that the majority of isolates displayed resistance to several of the investigated factors.
3.3. Assessment of the Antimicrobial Activity of Isolates
To detect the antimicrobial activity, a deferred antagonism assay was used. After overnight aerobic incubation at 37 °C, the plates were checked for the formation of inhibition zones around the producer colonies. The diameters of the inhibition zones were measured in millimeters. Microbial cultures were investigated for antagonism against pathogenic and conditionally pathogenic microorganisms (
Figure 1 and
Table 5), including lactobacilli, streptococci, and yeast. It is known that yeast also can suppress microorganisms, known as the “killer effect of yeast.”
The antimicrobial activity of the isolated cultures was studied in Petri dishes. The test strains used were E. coli, S. aureus, Pseudomonas sp., Candida sp., and B. subtilis. Cultures ST, BD, LX, and LM did not have antimicrobial activity against the studied pathogens of infectious diseases. Ten isolates (66.7%) were active against B. subtilis and Staphylococcus aureus, respectively. Isolate K showed only a low degree of activity (2.0 mm) to B. subtilis. Three isolates also have low activity against B. subtilis and S. aureus: 2.0–4.0 mm.
The remaining isolates are suppressed from three to four test cultures: isolates LP, LB, P-2, S-2, C-1, Sh-1, SK. Activity figures range from low to high. The highest numbers are for isolate LP to B. subtilis (13.3 mm), E. coli (19.3 mm); isolate LB to E. coli (21.7 mm), S. aureus (14.0 mm); isolate S-2 to B. subtilis (15.5 mm), E. coli (12.0 mm), S. aureus (16.0 mm); isolate C-1 to E. coli (11.0 mm); isolate Sh-1 to S. aureus (15.0 mm).
So, the most promising are the LP, LB, S-2, C-1, and Sh-1 isolates, which exhibit activity against several pathogens and have optimal antagonism numbers.
3.4. Identification of Isolates using Nucleotide Sequence Analysis of the 16s rRNA Gene
Identification of 13 bacterial cultures and identification of 2 fungal cultures was carried out by determining the direct nucleotide sequence of the 16S rRNA fragment and ITS gene, followed by determination of nucleotide identity with sequences deposited in the international Gene Bank database, as well as construction of phylogenetic trees with nucleotide sequences of reference strains. DNA was isolated and then its concentration was determined using a spectrophotometer. The main wavelengths used to measure DNA absorption are 260 nm (UV region) and 280 nm (protein component of DNA). The DNA concentration is given in
Table 6.
The PCR reaction was performed with universal primers [
20,
21] 8f (5′-AgAgTTTgATCCTggCTCAg-3′) and 806R (5′-ggACTACCAgggTATCTAAT-3′) for bacterial cultures and ITS 5—ggaagtaaaagtcgtaacaagg, ITS 4—tcctccgcttattgatatgc for yeast cultures. Analysis of amplified target DNA fragments was carried out using the DNA fragment separation method. In all samples, a specific fragment of approximately 800 and 500 bp in size was amplified. No PCR products are observed in the negative control sample, which indicates the absence of contamination in the reaction performed (
Figure 2).
Purification of PCR products from unbound primers and deoxynucleotide triphosphates was carried out by magnetic cleaning using magnetic silica gel [
22].
The sequencing reaction was then performed using the BigDye
® Terminator v3.1 Cycle Sequencing Kit (Applied Biosystems) according to the manufacturer’s instructions, followed by fragment separation on a 3730xl DNA Analyzer (Applied Biosystems). The obtained nucleotide sequences were analyzed and combined into a common sequence in SeqMan software (DNA Star) with the removal of fragments of primer nucleotide sequences that had a low-quality score. The obtained sequences were identified in GenBank using the BLAST algorithm. The results of comparison with reference strains are shown in
Table 7. According to the preliminary data obtained, it is clear that some cultures have several variations in species.
Taking into account the literature data indicating the availability of nucleotide sequences in international banks GeneBank (
http://www.ncbi.nlm.nih.gov/ (accessed on 1 September 2023)), Ribosomal Database Project (RDP-II) (
http://rdp.cme.msu.edu/html/ (accessed on 1 September 2023)), errors, we additionally constructed phylogenetic trees with nucleotide sequences of genes of reference strains of these species (
http://www.bacterio.net (accessed on 1 September 2023)). The analysis included nucleotide sequences of the 16S rRNA gene and ITS gene, phylogenetically the most related microorganisms.
To construct phylogenetic trees, Mega X software (version 10.2.6) was used. The Muscle algorithm was used to align nucleotide sequences; trees were constructed using the nearest neighbor-joining method (Neighbor-Joining NJ). They are presented in
Figure 3,
Figure 4,
Figure 5,
Figure 6,
Figure 7,
Figure 8 and
Figure 9.
As seen in
Figure 3, isolates P-2 and LP are situated on the same branch as
Lactiplantibacillus pentosus. Samples S-2 and LB are positioned on the same branch as
Lactiplantibacillus plantarum.
In
Figure 4, the AK sample is located in the same branch with
Lacticaseibacillus casei and
Lacticaseibacillus paracasei.
As can be seen in
Figure 5, samples BD and LX are located in the same branch with
Lactobacillus delbrueckii subsp.
As seen in
Figure 6, strains K and SK are positioned on the same phylogenetic branch as the bacteria
Lactococcus cremoris,
Lactococcus lactis,
Lactococcus lactis subsp., and
Streptococcus lactis.
Sample LM is located on one branch with
Enterococcus durans, while sample KS is located on one branch with
Enterococcus faecium (
Figure 7).
Based on the nucleotide sequence analysis of strain ST in BLAST, its maximum identity was determined with strains belonging to the group
Streptococcus thermophilus. Reference sequences of these strains were used for subsequent construction of the phylogenetic tree (
Figure 8).
As you can see, sample C-1 is located on the same branch as
Pichia kudriavzevii, Pichia cecembensis, and
Pichia sporocuriosa (
Figure 9). Given the high identity of these subspecies, reliable identification requires analysis of the nucleotide sequence of genes encoding proteins or phenotypic analysis.
Out of the 15 cultures analyzed, 9 were successfully identified to the species level, representing diverse bacterial genera such as
Lactobacillus,
Lactococcus,
Enterococcus,
Lactiplantibacillus, and
Streptococcus. Additionally, four isolates were classified at the genus level, including
Lactiplantibacillus,
Lacticaseibacillus,
Lactococcus, and
Pichia. However, due to technical constraints, genetic testing was not completed for two isolates, namely Str and Sh-1. The genetic identification results serve as valuable molecular–biological characteristics for these strains. To finalize the species assignment for the four cultures that lacked genetic testing, biochemical identification was conducted. This involved assessing carbohydrate fermentation on an Andrade indicator medium from HiMedia Laboratories Pvt. Ltd., India (
Table 8).
This method leverages the variability in microorganisms’ ability to ferment carbohydrates into acidic metabolites, enabling their differentiation and identification. Specific carbohydrates were introduced into the base medium, accompanied by a chemical indicator that undergoes a color change in response to acid formation during carbohydrate fermentation.
Probiotic LAB isolates were identified based on their morphological, physiological, and biochemical characteristics using the Bergey identification method [
12]. The isolated yeast culture has high assimilating activity for glucose, cellobiose, fructose, maltose, mannitol, mannose, and raffinose, but is weak in the metabolism of galactose, trehalose, and arabinose. The yeast culture was identified based on the determinant [
31]. Based on the results of the biochemical properties of the culture LP, AK, SK, identified as
Lactiplantibacillus pentosus,
Lacticaseibacillus casei,
Lactococcus lactis, and yeast C-1 as
Pichia kudriavzevii. The summary results of strain identification, comprising both gene fragment analysis and biochemical properties, are presented in
Table 9.
4. Discussion
Fermented milk cultures, members of the
Lactobacillaceae family, are united by their lactic acid-secreting abilities. This family encompasses lactobacilli, lactococci, lactic streptococci, and pediococci. These microorganisms are isolated from sources such as milk, lactic acid products, fermented goods, berries, grains, plants, and human biotopes, notably the large intestine. Strains isolated from infant feces exhibit exceptional probiotic efficacy. LABs, Gram-positive bacteria, play pivotal roles in various food fermentation processes [
32].
The lactic acid produced by lactobacilli possesses bactericidal effects and reduces environmental pH, creating unfavorable conditions for many microorganisms. Some strains, like
L. acidophilus, produce hydrogen peroxide—a potent antiseptic—and other peroxide compounds [
32]. Additionally, specific polypeptides (bacteriocins) with varying strengths and antibiotic spectra contribute to the acidification of the environment, preventing the development of other microorganisms [
33].
The inhibitory effects of lactobacilli on intestinal pathogens have been demonstrated in studies [
34]. For instance, researchers highlighted the inhibition of pathogen growth by
L. casei through the measurement of growth inhibition diameters on agar plates pre-incubated with
L. casei.
L. casei notably inhibits the growth of
S. aureus,
Listeria monocytogenes,
S. typhimurium,
E. coli,
Cl. difficile, and
Cl. perfringens. Although not belonging to LAB, bacteria of the genus
Bifidobacterium are considered probiotic and starter cultures due to their ability to suppress opportunistic and pathogenic microorganisms [
6,
35]. Most species of both
Bifidobacterium and
Lactobacillus are characterized by the production of organic acids.
Bacilli and yeast are common probiotics, producing various biologically active substances and exhibiting the ability to suppress pathogenic microflora. Yeasts, found in soil, plants, and macroorganism biotopes, have gained attention for their mineral and vitamin content, peptides, proteins, and resistance to industrial conditions compared to bacteria. Yeasts, particularly
Saccharomycetes, often display antagonistic effects, including the “killer effect” resulting from toxin release [
15]. The study by Bajaj et al. [
15] marked the first documentation of the killer phenomenon in
Pichia kudriavzevii RY55. The toxin from
P. kudriavzevii RY55 demonstrated antimicrobial activity against common pathogens such as
Escherichia coli,
Enterococcus faecalis,
Klebsiella sp.,
Staphylococcus aureus,
Pseudomonas aeruginosa, and
Pseudomonas alcaligenes, showing promise as a metabiotic for treating various intestinal diseases. Consequently, attention has turned towards yeast of the genus
Pichia in probiotics [
23,
36,
37].
The study by Alkalbani et al. [
36] aimed to isolate yeast from fermented milk and non-dairy products. Twelve yeast isolates demonstrated robust survival under acidic conditions, cholesterol reduction abilities, bile salt hydrolysis, heat stability, hydrophobicity, strong coaggregation, autoaggregation after 24 h, and potent antimicrobial activity. Yeasts included
Candida albicans (1 strain),
Saccharomyces cerevisiae (1 strain), and
Pichia kudriavzevii (10 strains).
To evaluate dairy yeasts’ probiotic potential, Kumura et al. [
24] assessed eight species:
Candida humilis,
Debaryomyces hansenii,
Debaryomyces occidentalis,
Kluyveromyces lactis,
Kluyveromyces lodderae,
Kluyveromyces marxianus,
Saccharomyces cerevisiae, and
Yarrowia lipolytica. Materials were sourced from commercial blue cheese and kefir. Evaluation criteria included adhesion, growth under acidic conditions, and gastrointestinal tract simulation. Notably,
K. lactis emerged as the most promising probiotic due to its adhesion and bile salt resistance.
Numerous studies highlight the effects of stress factors on microorganisms. Probiotic cultures exhibit better tolerance to increased acidity, bile salts, and NaCl [
25,
26,
27]. For instance, lactobacilli demonstrate robust growth rates at pH 2.0–4.0 [
26]. A study [
25] evaluated the probiotic properties of LAB isolated from various Ethiopian foods. Ninety LAB isolates were tested, with 4 (4.44%) showing survival rates of 45.35–97.11% and 38.40–90.49% at pH values of 2, 2.5, and 3 for 3 and 6 h, respectively. These acid-tolerant isolates also exhibited resilience to 0.3% bile salt for 24 h, with survival rates ranging from 91.37 to 97.22%. Acid- and bile-salt-tolerant lactobacilli were found to inhibit certain foodborne pathogenic bacteria, with variable susceptibility to antibiotics. Consequently, four
Lactobacillus strains were selected for probiotic product development.
Probiotic strains must exhibit stress resistance to be effective. Notably, microorganisms sourced from human biotopes and indigenous products display enhanced efficacy. Recent efforts have focused on isolating industrially valuable strains from ethnic products, showcasing unique properties. For instance, Indonesian scientists isolated
Lactobacillus bacteria from the traditional dairy product dangke—Gram-positive, non-motile rods resistant to pH 2.0 with probiotic potential [
26].
In another research [
38], LAB was isolated from 66 samples of traditional Mongolian products, identifying and assessing probiotic potential. Isolates included lactobacilli and streptococci, with 10 strains selected as probiotics. Remarkably, 6 strains were isolated from camel milk-based products, representing
Lactobacillus plantarum and
Lactobacillus paracasei species.
Another study [
39] investigated LAB from dairy products in Bahir Dar and its environs in Ethiopia. The study, similar to ours, utilized milk, cheese, and yogurt for isolation. LAB and bifidobacteria were isolated, exhibiting morphocultural characteristics akin to our studies. These acid-resistant strains showed promise for further research.
Antimicrobial activity against pathogens is a key focus, echoed in our research and studies worldwide. A study [
40] assessed the antagonistic effects of lactobacilli isolated from local dairy products against standard strains of
S. aureus (ATCC-6538),
B. subtilis (ATCC-12711), and
P. aeruginosa (ATCC-27853) in Ahwaz, Iran. Antagonism was assessed through agar diffusion, revealing three strains with potent antimicrobial activity—
Lactobacillus alimentarius,
Lactobacillus sate, and
Lactobacillus collinoides.
The issue of diseases stemming from disruptions in the microbiota of specific habitats, compounded by the antibiotic resistance of infectious agents, is multifaceted. Addressing this challenge involves leveraging beneficial living microbes (probiotics) to combat these pathogens. This objective is echoed in various studies, including the research by Tadesse Bonger et al. [
23], which identified dominant species of LAB and yeast in the cereal grain “Tefa” through morphological, physiological, and biochemical characteristics. Predominant bacteria included
Lactobacillus fermentum,
Lactobacillus brevis,
Lactobacillus plantarum,
Bacillus subtilis, and
Enterococcus casseliflavus, while predominant yeasts comprised
Saccharomyces cerevisiae,
Candida krusei, and
Pichia kudriavzevii. These strains exhibited antimicrobial activity against various opportunistic microorganisms. Similarly, another study [
26] focused on isolating probiotic microorganisms, primarily
Lactobacillus species, from the traditional product “Dangke”.
In another study, 63 LAB cultures with probiotic potential were isolated from indigenous Bangladeshi raw milk [
41], while LAB (93 species) and yeast (over 10 species) with probiotic potential were extracted from traditional Iranian fermented camel milk “Chal” [
42]. The proliferation of research in this area underscores the demand and potential of promising microorganisms. Notably, the isolation of LAB from traditional food products has become increasingly common, mirroring findings observed in our study.
Our predominant microorganisms belonged to the genus
Lactobacillus. The samples of homemade and factory-produced dairy products were purchased in Kazakh markets. Stress resistance was examined concerning various factors including pH levels, temperature, salt concentration, glucose, ethanol, and peroxides. The optimal growth conditions for our cultures were identified as follows: a temperature of 27 °C, pH levels ranging from 6.8 to 7.0 and 8.0 to 9.6, sodium chloride concentrations of 2%, 4%, and 6% in the medium, with 4% ethanol proving to be more optimal, and glucose concentrations ranging from 30% to 50%. In terms of peroxide exposure, only six cultures exhibited resistance to a concentration of 2 mmol/L. While acid tolerance is often considered a desirable trait for probiotic microorganisms, it is not an absolute requirement. Probiotics must be able to survive the acidic environment of the stomach to reach the intestines, where they can exert their beneficial effects. However, not all probiotic strains need to be highly acid-tolerant to fulfill their function. Some probiotic strains have evolved mechanisms to withstand acidic conditions more effectively, which can enhance their survival rate during transit through the stomach. However, other factors, such as the presence of protective matrices (e.g., encapsulation) or adhesion properties, can also contribute to probiotic viability and colonization in the gut, even if the strains are not extremely acid-tolerant [
43]. In summary, while acid tolerance is advantageous for probiotics, it is not the sole determinant of their efficacy. Other factors, including strain-specific characteristics and environmental conditions, also play significant roles in determining probiotic survival and functionality.
Our findings, as delineated in the referenced study on the isolation of LAB from teff fermentation products [
23], underscored the robustness of LAB isolates across various salt concentrations. Salt tolerance assays revealed the growth and turbidity production of all identified LAB isolates at disparate salt levels. Distinct variations in growth density and turbidity were noted, with optimal growth observed at 8% and 10% NaCl concentrations, contrasting with diminished growth at 4%. This observation suggests that LAB species isolated from teff fermentation products exhibit resilience across a spectrum of salt concentrations, spanning 4–10%. In general, our analysis revealed the resilience of most strains to multiple stress factors. Notably,
Lacticaseibacillus cultures exhibited resistance to all stress factors, such as
Lacticaseibacillus casei AK and
Enterococcus faecium KS, indicative of their adaptability to diverse conditions.
Antimicrobial activity is a pivotal characteristic of potential probiotic strains. In the study by Guesh Mulaw [
25], significant efforts were invested in selecting LAB originating from traditional Ethiopian fermented foods based on key technological, functional, and safety criteria to obtain potential probiotic strains. Four effective probiotic isolates belonging to the genus
Lactobacillus were identified at the strain level using sequence comparisons of 16 S rDNA genes. These isolates exhibited varying degrees of antagonism towards
S. aureus,
L. monocytogenes,
S. typimurium, and
E. coli, corroborating our own findings (
Table 5).
Abduxukur et al. screened strains with antioxidant potential from lactic acid bacteria and yeasts isolated from traditional Xinjiang fermentation products [
44]. They found that
Lacticaseibacillus paracasei NM-12,
Enterococcus faecium UM-12 and NM-11, and
Pichia fermentans QY-4 exhibited effective antioxidant enzyme activities, with superoxide dismutase activity reaching up to 9.105 ± 0.428 U/mL, glutathione peroxidase activity up to 0.1396 ± 0.009 U/mL, and catalase activity up to 97.289 ± 0.535 U/mL. Zhao et al. studied koumiss, a traditional fermented dairy product in Inner Mongolia and Central Asia, and explored the properties of potential probiotics in it through in vitro assays and whole-genome sequencing [
45]. They identified a strain close to
Lacticaseibacillus paracasei, which effectively inhibited pathogenic bacteria growth, tolerated simulated gastrointestinal conditions, and showed hydrophobicity, aggregation, and antioxidant properties without antibiotic resistance or toxic effects in mice. Saboori et al. collected kashk samples from Fars (Abadeh) and Razavi Khorasan (Kalat) provinces in Iran, isolating fifteen bacteria for physiological and biochemical assays [
46]. Eight isolates identified as LAB included
Enterococcus faecium,
Pediococcus pentosaceus,
Lactococcus lactis, Enterococcus faecalis,
Enterococcus mundtii, and
Lactiplantibacillus plantarum.
P. pentosaceus VNK-1 (KK4) and
P. pentosaceus H11 (KF3) demonstrated the best probiotic properties, including high resistance to bile salts, strong antimicrobial activity, and excellent adhesion capabilities to intestinal epithelial cells. Dobreva et al. studied the traditional Bulgarian fermented product “katak,” isolating 18 lactic acid bacteria from artisanal samples made in Northwest Bulgaria [
47]. Using a polyphasic taxonomic approach, they identified 13 strains, with
Lactiplantibacillus plantarum being dominant. In vitro tests showed these strains exhibited a broad spectrum of activity against food-borne and human pathogens, with promising probiotic features such as the production of lactate, acetate, and butyrate, necessitating further characterization and analysis of their post-metabolites. Alemneh et al. evaluated the suitability of a teff-based substrate for delivering the potential probiotics
Lactobacillus rhamnosus GG (LGG) and
Lactobacillus plantarum A6 (LA6) to develop probiotic functional beverages [
48]. Single-strain and mixed-strain fermentations were performed without pH control, with both strains achieving high growth and producing lactic and acetic acids. The study concluded that whole grain teff flour could be used as a substrate to produce non-alcoholic functional probiotic beverages, with a combination of the two strains reducing fermentation time.
Our identification efforts involved selecting 15 candidates with the highest viable cell counts for technological use out of 33 isolates. Preliminary phylogenetic identification was conducted by sequencing a fragment of the 16S rRNA gene and the ITS gene, followed by matching nucleotide sequences with those deposited in the international GenBank database (
Table 7). Additionally, carbohydrate fermentation assays were conducted for ungenotyped strains (
Table 8). Our analyses revealed that the obtained cultures comprised bacteria of the genus
Lactobacillus,
Lactiplantibacillus,
Lacticaseibacillus,
Lactococcus,
Enterococcus,
Streptococcus, and yeast of the genus
Pichia. As previously noted, yeast cultures of
Pichia [
39,
40] have been recognized as promising [
49,
50].
In summary, our investigations unveiled probiotic strains with promising attributes, such as stress resistance and antimicrobial activity. Notable among these are the Lactiplantibacillus strains pentosus LP, argentoratensis LB, and plantarum S-2, as well as Lacticaseibacillus casei AK, Enterococcus faecium KS, and Pichia kudriavzevii C-1. These strains hold potential applications in the development of probiotic preparations and starter cultures for the production of functional products. Furthermore, their resilience to stress factors, including food processing conditions, suggests their viability for further in vivo evaluation as candidates for probiotic and starter culture production.